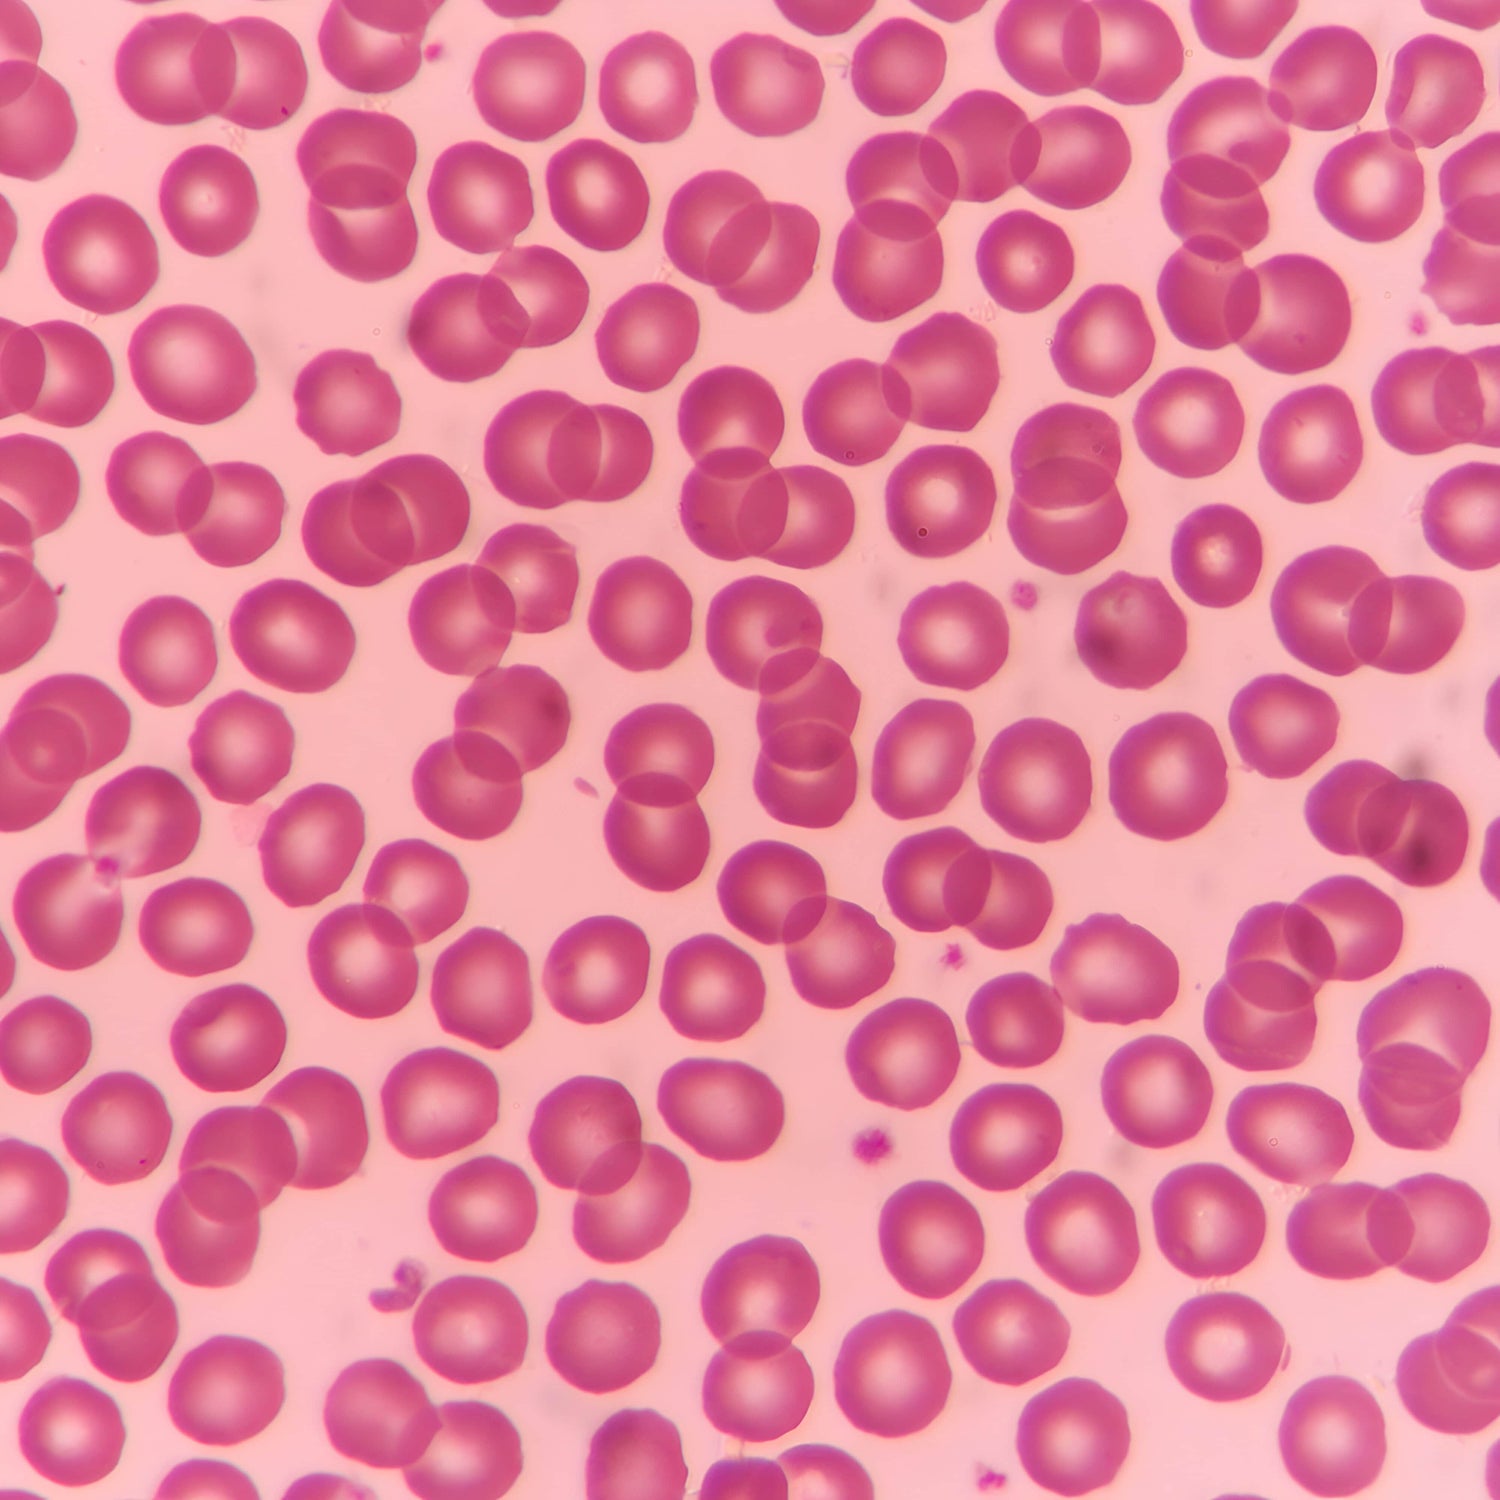

Colloidal Minerals Demystified
Colloidal minerals are suspended nanoparticles in a liquid, allowing for enhanced absorption by the body. Our products harness the power of Colloidal Gold, Silver, Zinc, Copper, and Iron—each with unique properties contributing to holistic well-being.

Key Benefits
- Colloidal Silver: Renowned for its antimicrobial properties, supporting immune health.
- Colloidal Gold: Potential benefits for cognitive function and overall mental well-being.
- Colloidal Zinc: Essential for immune function, wound healing, and maintaining healthy skin.
- Colloidal Copper: Aiding in collagen formation, supporting skin, and promoting overall vitality.
- Colloidal Iron: Crucial for red blood cell formation, enhancing energy levels.




Research and Studies: Backed by Science
We take pride in our commitment to scientific rigor. Our Colloidal Minerals are not just natural; they are supported by relevant scientific studies that validate their efficacy. Explore the depth of research demonstrating the potential benefits of colloidal minerals in promoting health and vitality.
-
COLLOIDAL GOLD
Learn MoreFrom targeted drug delivery and diagnostic imaging to photothermal therapy and immune modulation, colloidal gold is poised to revolutionize healthcare. As research progresses and clinical trials unfold, we can anticipate a future where colloidal gold plays an increasingly significant role in improving human health and well-being.
-
COLLOIDAL SILVER
Learn MoreSilver nanoparticles hold immense promise as therapeutic agents for various medical applications. Their unique properties, including broad-spectrum antimicrobial activity, wound healing potential, and drug delivery capabilities make them attractive candidates for innovative medical interventions.
-
COLLOIDAL IRON
Learn MoreColloidal iron is an emerging alternative to traditional oral iron supplements. Improved absorption, minimal side effects, and potential applications beyond anemia treatment make it a valuable tool for healthcare professionals seeking to optimize iron delivery and address various health conditions.
-
COLLOIDAL COPPER
Learn MoreThe anti-inflammatory, antioxidant, antimicrobial, wound-healing and skin-enhancing properties of Colloidal Copper make it a versatile substance with potential applications across a wide range of medical fields.
-
COLLOIDAL ZINC
Learn MoreColloidal zinc is an effective therapeutic agent for various medical conditions. Enhanced bioavailability, potential to modulate cellular processes, and anti-inflammatory properties are several potential benefits it offers when compared to traditional zinc supplements.
-
METHYLENE BLUE
Learn MoreLow-dose Methylene Blue (MB) is rapidly emerging as a promising candidate for combating various age-related diseases. With a long history in medicine, this synthetic compound is an attractive option to many health and wellness minded consumers and experts alike for its powerful antioxidant properties, and ability to oxygenate cells in the body.



